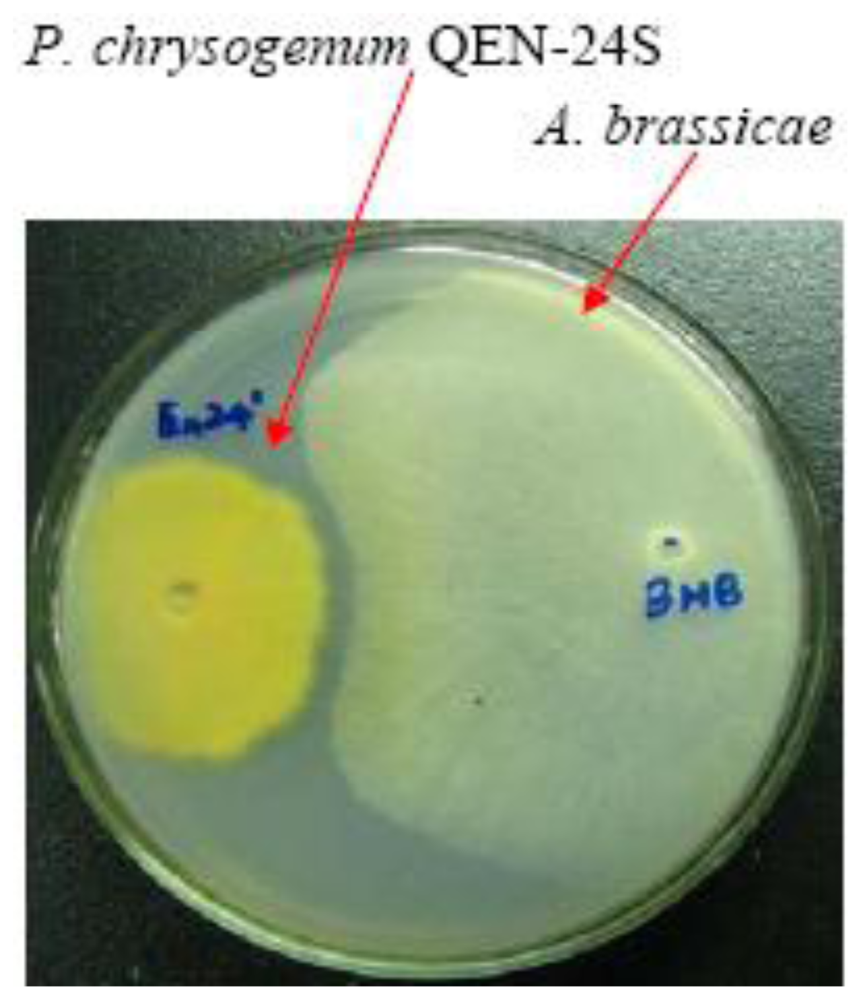
Marinedrugs 09 00059f1

Secondary Metabolites from a Marine-Derived Endophytic Fungus Penicillium chrysogenum QEN-24S
Abstract
:1. Introduction
2. Results and Discussion
2.1. Bioassay-Guided Isolation
2.2. Structural Elucidation of the New Compounds
2.3. Biological Activities of the Isolated Compounds
3. Experimental Section
3.1. General
3.2. Fungal Material
3.3. Extraction and Isolation
3.4. Preparation of the (R)- and (S)-MTPA Ester Derivatives of Compound 1 [25]
3.5. Dual Culture Test
3.6. Antifungal Assay
3.7. Cytotoxicity Assay
4. Conclusions
Acknowledgements
- Samples Availability: Available from the authors.
References
- Bugni, TS; Ireland, CM. Marine-derived fungi: A chemically and biologically diverse group of microorganisms. Nat Prod Rep 2004, 21, 143–163. [Google Scholar]
- Blunt, JW; Copp, BR; Hu, WP; Munro, MHG; Northcote, PT; Prinsep, MR. Marine natural products. Nat Prod Rep 2008, 25, 35–94. [Google Scholar]
- Blunt, JW; Copp, BR; Hu, WP; Munro, MHG; Northcote, PT; Prinsep, MR. Marine natural products. Nat Prod Rep 2009, 26, 170–244. [Google Scholar]
- Blunt, JW; Copp, BR; Munro, MHG; Northcote, PT; Prinsep, MR. Marine natural products. Nat Prod Rep 2010, 27, 165–237. [Google Scholar]
- Zhang, Y; Li, XM; Wang, BG. Nigerasperones A–C, new monomeric and dimeric naphtho-γ-pyrones from a marine alga-derived endophytic fungus Aspergillus niger EN-13. J Antibiot 2007, 60, 204–210. [Google Scholar]
- Zhang, Y; Wang, S; Li, XM; Cui, CM; Feng, C; Wang, BG. New sphingolipids with a previously unreported 9-methyl-C20-sphingosine moiety from a marine algous endophytic fungus Aspergillus niger EN-13. Lipids 2007, 42, 759–764. [Google Scholar]
- Zhang, Y; Li, XM; Proksch, P; Wang, BG. Ergosterimide, a new natural Diels-Alder adduct of a steroid and maleimide in the fungus Aspergillus niger. Steroids 2007, 72, 723–727. [Google Scholar]
- Zhang, Y; Li, XM; Wang, CY; Wang, BG. A new naphthoquinoneimine derivative from the marine algal-derived endophytic fungus Aspergillus niger EN-13. Chin Chem Lett 2007, 18, 951–953. [Google Scholar]
- Wang, S; Li, XM; Teuscher, F; Li, DL; Diesel, A; Ebel, R; Proksch, P; Wang, BG. Chaetopyranin, a benzaldehyde derivative, and other related metabolites from Chaetomium globosum, an endophytic fungus derived from the marine red alga Polysiphonia urceolata. J Nat Prod 2006, 69, 1622–1625. [Google Scholar]
- Gao, SS; Li, XM; Wang, BG. Perylene derivatives produced by Alternaria alternata, an endophytic fungus isolated from Laurencia species. Nat Prod Commun 2009, 4, 1477–1480. [Google Scholar]
- Cui, CM; Li, XM; Li, CS; Sun, HF; Gao, SS; Wang, BG. Benzodiazepine alkaloids from marine-derived endophytic fungus Aspergillus ochraceus. Helv Chim Acta 2009, 92, 1366–1370. [Google Scholar]
- Cui, CM; Li, XM; Li, CS; Proksch, P; Wang, BG. Cytoglobosins A–G, cytochalasans from a marine-derived endophytic fungus, Chaetomium globosum QEN-14. J Nat Prod 2010, 73, 729–733. [Google Scholar]
- Samson, RS; Hadlok, R; Stolk, AC. A taxonomic study of the Penicillium chrysogenum series. Antonie Van Leeuwenhoek 1977, 43, 169–175. [Google Scholar]
- Soper, QF; Whitehead, CW; Behrens, OK; Corse, JJ; Jones, RG. Biosynthesis of penicillins. VII. Oxy- and mercaptoacetic acids. J Am Chem Soc 1948, 70, 2849–2855. [Google Scholar]
- Bringmann, G; Lang, G; Gulder, TAM; Tsuruta, H; Muhlbacher, J; Maksimenka, K; Steffens, S; Schaumann, K; Stohr, R; Wiese, J; Imhoff, JF; Perovic-Ottstadt, S; Boreiko, O; Muller, WEG. The first sorbicillinoid alkaloids, the antileukemic sorbicillactones A and B, from a sponge-derived Penicillium chrysogenum strain. Tetrahedron 2005, 61, 7252–7265. [Google Scholar]
- Maskey, RP; Grun-Wollny, I; Laatsch, H. Isolation, structure elucidation and biological activity of 8-O-methylaverufin and 1,8-O-dimethylaverantin as new antifungal agents from Penicillium chrysogenum. J Antibiot 2003, 56, 459–463. [Google Scholar]
- Yan, HJ; Gao, SS; Li, CS; Li, XM; Wang, BG. Chemical constituents of a marine-derived endophytic fungus Penicillium commune G2M. Molecules 2010, 15, 3270–3275. [Google Scholar]
- Romeyke, Y; Keller, M; Kluge, H; Grabley, S; Hammann, P. Secondary metabolites by chemical screening-13. Enantioselective synthesis of δ-lactones from streptenol A, a chiral building block from streptomyces. Tetrahedron 1991, 47, 3335–3346. [Google Scholar]
- Oh, DC; Gontang, EA; Kauffman, CA; Jensen, PR; Fenical, W. Salinipyrones and pacificanones, mixed-precursor polyketides from the marine actinomycete Salinispora pacifica. J Nat Prod 2008, 71, 570–575. [Google Scholar]
- Hochlowski, JE; Faulkner, DJ. Antibiotics from the marine pulmonate Siphonaria diemenensis. Tetrahedron Lett 1983, 24, 1917–1920. [Google Scholar]
- Lindel, T; Jensen, PR; Fenical, W. Lagunapyrones A–C: cytotoxic acetogenins of a new skeletal class from a marine sediment bacterium. Tetrahedron Lett 1996, 37, 1327–1330. [Google Scholar]
- Diliberto, JJ; Srinivas, P; Overstreet, D; Usha, G; Burka, LT; Birnbaum, LS. Metabolism of citral, an α,β-unsaturated aldehyde, in male F344 rats. Drug Metab Dispos 1990, 18, 866–875. [Google Scholar]
- Fkyerat, A; Burki, N; Tabacchi, R. Enantioselective synthesis of 3-hydroxycitronellic acid isolated from Ceratocystis fimbriata sp. platani. Tetrahedron: Asymmetry 1996, 7, 2023–2028. [Google Scholar]
- Madyastha, MK; Renganathan, V. Biodegradation of acetates of geraniol, nerol and citronellol by P. incognita: Isolation and identification of metabolites. Indian J Biochem Biophys 1983, 20, 136–140. [Google Scholar]
- Wang, BG; Ebel, R; Wang, CY; Wray, V; Proksch, P. New methoxylated aryltetrahydronaphthalene lignans and a norlignan from Aglaia cordata. Tetrahedron Lett 2002, 43, 5783–5787. [Google Scholar]
- Imtiaj, A; Lee, TS. Antagonistic effect of three Trichoderma species on the Alternaria porri pathogen of onion blotch. World J Agric Sci 2008, 4, 13–17. [Google Scholar]
- Al-Burtamani, SKS; Fatope, MO; Marwah, RG; Onifade, AK; Al-Saidi, SH. Chemical composition, antibacterial and antifungal activities of the essential oil of Haplophyllum tuberculatum from Oman. J Ethnopharmacol 2005, 96, 107–112. [Google Scholar]
- Bergeron, RJ; Cavanaugh, PF, Jr; Kline, SJ; Hughes, RG, Jr; Elliott, GT; Porter, CW. Antineoplastic and antiherpetic activity of spermidine catecholamide iron chelators. Biochem Biophys Res Commun 1984, 121, 848–854. [Google Scholar]

| No. | 1 b | 2 c | ||
|---|---|---|---|---|
| 1H | 13C | 1H | 13C | |
| 1 | 170.33 s | 172.31 s | ||
| 2 | 2.61 dd (17.6, 5.1) | 38.66 t | 2.54 dd (17.7, 3.5) | 37.81 t |
| 2.73 dd (17.6, 3.7) | 2.71 dd (17.7, 4.7) | |||
| 3 | 4.38 m | 62.83 d | 4.25 m | 61.96 d |
| 4 | 1.73 m | 36.13 t | 1.72 m | 35.14 t |
| 1.95 m | 1.93 m | |||
| 5 | 4.68 tdd (7.9, 5.2, 3.0) | 75.68 d | 4.69 m | 76.46 d |
| 6 | 1.59 m | 35.49 t | 1.61 m | 35.32 t |
| 1.73 m | 1.70 m | |||
| 7 | 1.41 m | 25.11 t | 1.36 m | 24.86 t |
| 8 | 1.30 m | 26.39 t | 1.37 m | 26.49 t |
| 9 | 1.08 m | 36.55 t | 1.19 m | 38.58 t |
| 1.30 m | 1.40 m | |||
| 10 | 1.54 m | 29.88 d | 1.66 m | 28.37 d |
| 11 | 0.93 m | 44.79 t | 1.30 m | 48.71 t |
| 1.22 m | 1.48 m | |||
| 12 | 1.45 m | 30.11 d | 72.37 s | |
| 13 | 1.14 m | 32.67 t | 1.45 m | 38.19 t |
| 1.35 m | 1.60 m | |||
| 14 | 1.38 m | 36.55 t | 1.47 m | 33.19 t |
| 1.48 m | 1.52 m | |||
| 15 | 3.76 m | 68.56 d | 3.69 m | 67.85 d |
| 16 | 1.19 d (6.9) | 23.54 q | 1.16 d (6.2) | 22.17 q |
| 17 | 0.85 d (6.4) | 20.28 q | 1.15 s | 25.91 q |
| 18 | 0.84 d (6.4) | 20.26 q | 0.97 d (6.6) | 21.01 q |
| No. | 3 | 4 | ||
|---|---|---|---|---|
| 1H | 13C | 1H | 13C | |
| 1 | 3.87 brs | 61.67 t | 4.35 dd (11.5, 6.0) 4.46 dd (11.5, 4.5) | 67.38 t |
| 2 | 5.20 m | 78.01 d | 4.03 m | 70.73 d |
| 3 | 3.87 brs | 61.67 t | 3.66 d (5.4) | 64.28 t |
| 4 | 172.06 s | 172.43 s | ||
| 5 | 106.06 s | 105.68 s | ||
| 6 | 166.16 s | 166.29 s | ||
| 7 | 6.23 d (2.5) | 101.68 d | 6.25 d (2.5) | 101.73 d |
| 8 | 163.26 s | 163.35 s | ||
| 9 | 6.28 d (2.5) | 112.32 d | 6.29 d (2.5) | 112.37 d |
| 10 | 144.68 s | 144.93 s | ||
| 11 | 2.51 s | 24.36 q | 2.51 s | 24.45 q |
| No. | 1H | 13C | No. | 1H | 13C |
|---|---|---|---|---|---|
| 1 | 176.37 s | 7 | 130.56 s | ||
| 2 | 2.57 d (15.8) 2.50 d (15.8) | 44.72 t | 8 | 4.44 s | 70.09 t |
| 3 | 71.07 s | 9 | 1.66 s | 13.83 q | |
| 4 | 1.61 m | 41.12 t | 10 | 1.29 s | 26.53 q |
| 5 | 2.14 m | 22.27 t | OAc | 2.07 s | 20.92 q |
| 6 | 5.44 t (6.9) | 128.84 d | 171.16 s |
| AMPB b | 1 | 2 | 3 + 4 | 5 | |
|---|---|---|---|---|---|
| A. niger | 24 | + | − | − | + |
| A. brassicae | 18 | 6 | − | − | 17 |
© 2011 by the authors; licensee Molecular Diversity Preservation International, Basel, Switzerland This article is an open-access article distributed under the terms and conditions of the Creative Commons Attribution license (http://creativecommons.org/licenses/by/3.0/).
Share and Cite
Gao, S.-S.; Li, X.-M.; Du, F.-Y.; Li, C.-S.; Proksch, P.; Wang, B.-G. Secondary Metabolites from a Marine-Derived Endophytic Fungus Penicillium chrysogenum QEN-24S. Mar. Drugs 2011, 9, 59-70. https://doi.org/10.3390/md9010059
Gao S-S, Li X-M, Du F-Y, Li C-S, Proksch P, Wang B-G. Secondary Metabolites from a Marine-Derived Endophytic Fungus Penicillium chrysogenum QEN-24S. Marine Drugs. 2011; 9(1):59-70. https://doi.org/10.3390/md9010059
Chicago/Turabian StyleGao, Shu-Shan, Xiao-Ming Li, Feng-Yu Du, Chun-Shun Li, Peter Proksch, and Bin-Gui Wang. 2011. "Secondary Metabolites from a Marine-Derived Endophytic Fungus Penicillium chrysogenum QEN-24S" Marine Drugs 9, no. 1: 59-70. https://doi.org/10.3390/md9010059
APA StyleGao, S.-S., Li, X.-M., Du, F.-Y., Li, C.-S., Proksch, P., & Wang, B.-G. (2011). Secondary Metabolites from a Marine-Derived Endophytic Fungus Penicillium chrysogenum QEN-24S. Marine Drugs, 9(1), 59-70. https://doi.org/10.3390/md9010059

